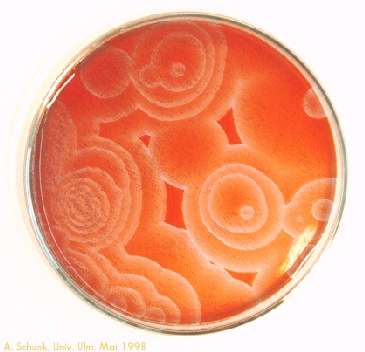

Experiment des Monats
Mai 1998
Belousov-Zhabotinsky-Reaktion

|
Experiment des Monats |
Geräte und Chemikalien:
Erlenmeyerkolben mit Stopfen, Kristallisier- oder Petrischale, Magnetrührer, ggf. Projektor
0,5 M Natriumbromat-Lösung,
1,5 M Malonsäure-Lösung,
5 M Schwefelsäure (halbkonzentriert!),
0,3 M Natriumbromid-Lösung,
0,01 M Ferroin-Lösung
Durchführung (räumliche Oszillation):
In einem Kolben zu 15 ml Bromat- und 3 ml Malonsäure-Lösung 2 ml Schwefelsäure
und 5 ml Bromid-Lösung geben. Bei Zugabe des Bromids entsteht zunächst Brom. Den
Kolben daher verschließen und so lange rühren/schütteln bis die braune
Brom-Farbe wieder verschwunden ist. Erst jetzt 5 ml Ferroin-Lösung zugeben, da der
Indikator sonst vom Brom zersetzt würde. Die Schale 2 - 3 mm hoch füllen und
möglichst ruhig lagern. (ggf. mit Kork-Scheibchen oder Schaumstoff "abfedern")
Es bilden sich meist konzentrische rote und blaue Kreise aus.
Durchführung (zeitliche Oszillation):
8 ml Bromat-Lösung, 10 ml Malonsäure-Lösung, 10 ml Schwefelsäure,
7 ml Wasser und 4 ml Bromid-Lösung zusammengeben und Gefäß verschließen.
Wenn sich das Gemisch entfärbt hat (Brom abgebaut ist), 1 ml Ferroin-Lösung
zugeben und den Ansatz ständig rühren. Nach kurzer Zeit beginnt die rot-blau-Oszillation,
die meist mehrere Stunden läuft.
Erklärung:
Eine Oszillation kann auftreten, so lange die Haupt-Reaktion, die freiwillig
abläuft und das ganze System "antreibt", sich weit außerhalb des
Gleichgewichtes befindet.
Weiterhin sind mehrere gekoppelte Reaktionen nötig, wobei diese
unterschiedliche Kopplungs-Konstanten besitzen. Man kann dies vergleichen
mit einer Standuhr: Die Gewichte (= Gesamtreaktion) treiben die Uhr (das
System) an, der Pendel schwingt zwischen zwei Zuständen. Den gekoppelten
Reaktionen entspricht in diesem Modell das Wechselspiel aus kinetischer
und potentieller Energie.
Die Gesamtreaktion ist bei der Belousov-Zhabotinsky-Reaktion
eine Bromierung der Malonsäure:
2 Br- + BrO3- + 3 H+ + 3 HOOC-CH2-COOH
 3 HOOC-CHBr-COOH + 3 H2O
3 HOOC-CHBr-COOH + 3 H2O
Es treten jedoch zahlreiche Zwischenprodukte auf, u.a. Brom (vor allem zu Beginn) und
CO2, es kommt daher gegen Ende zur Bildung kleiner Gasbläschen. Das System
pendelt ständig zwischen einem oxidierenden und reduzierenden Milieu.
In der "Original-Reaktion", wie sie von B. P. Belousov (1959, zeitlich) und A. M. Zhabotinsky
(1967, räumlich) beschrieben wurde, dienen Cer-Ionen als Katalysator und Redox-System
(Ce4+/Ce3+). Statt Cer können jedoch auch andere Redox-Paare
eingesetzt werden, besonders geeignet ist
Ferroin/Ferriin (tris-Phenanthrolin-Eisensulfat).
Bei diesem ist der Wechsel zwischen Ferroin (reduziert, orange-rot) und Ferriin (oxidiert, blau)
besonders gut sichtbar.
Bei der zeitlichen Oszillation wird die Lösung gerührt, durch die
Durchmischung liegt das gesamte System im oxidierten oder reduzierten
Zustand vor. Bleibt dagegen (bei der räumlichen Oszillation) eine dünne Schicht
in Ruhe, bilden sich kleine Mikrozustände aus, die jeweils für sich die Farbe
ändern.
Gefahren:




Natriumbromat wirkt brandfördernd, Malonsäure reizend, Ferroin
gesundheitsschädlich. Schwefelsäure ist ätzend, das zu Beginn der Reaktion
freiwerdende Brom ätzend und giftig! (Abzug!)
Entsorgung:
Die Lösungen als anorganische Abfälle entsorgen.
Literatur:
R. J. Field: "Eine oszillierende Reaktion"; Chemie in unserer Zeit, 7 (1973), 171-176
Nachdruck in: "Experimente aus der Chemie" - S. 129-138
R. Deuber: "Selbstorganisation", ETH Zürich / Kantonsschule Baden
H. Wenisch, O. Herrmann: "Oszillierende Reaktionen am Beispiel der
Belousov-Zhabotinsky-Reaktion"
Naturwissenschaften im Unterricht: Chemie, 1 (1990), Nr. 2, 35-39
 zurück zum aktuellen Experiment
zurück zum aktuellen ExperimentSeite erstellt am: Donnerstag, 30. April 1998,
A. Schunk.